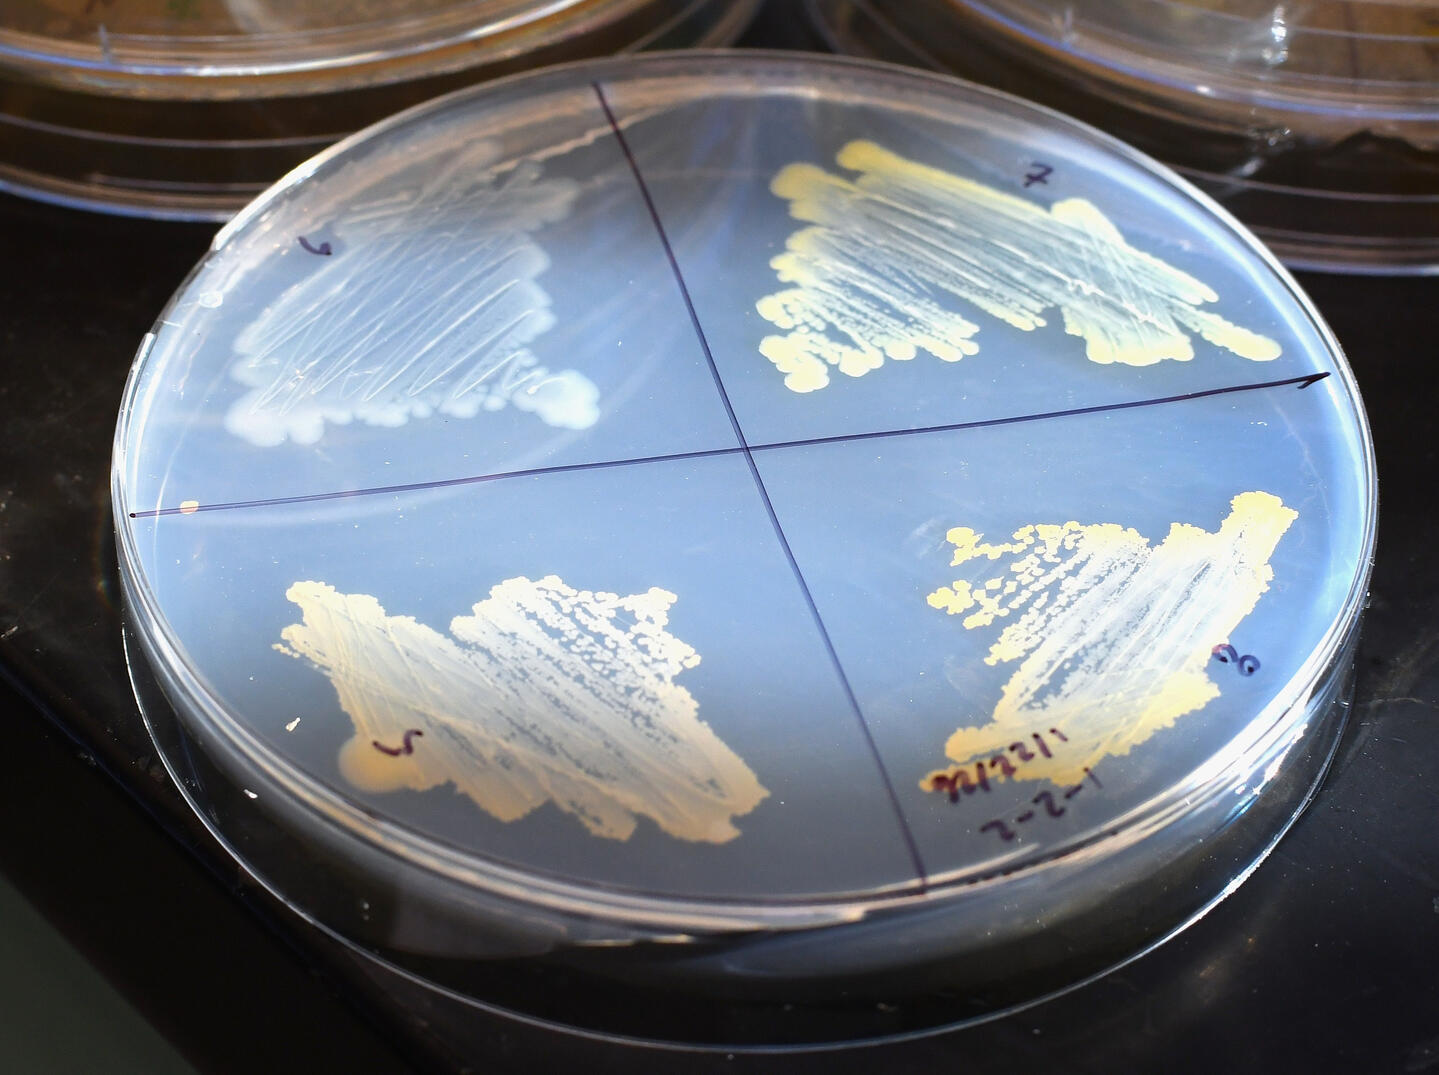
Milo Flint

The Holmes Lab leverages expertise in metabolic chemistry and synthetic biology to discover, evolve, and engineer the critical interactions that underlie plant-microbe symbioses. We aim to develop technologies to sustainably improve productivity and health of important regional crops.


Climate change-induced abiotic and biotic stressors pose a significant threat to agriculture and global food security. As a rising demand for food and negative impacts from climate change co-occur, transformational changes to our agricultural systems will be necessary to sustainably feed the planet. New technologies that leverage the plant microbiome to improve depleted soils, reduce crop loss, and replace energy-intensive fertilizers promise to contribute toward this transformation. Currently, the study of the plant microbiome is undergoing a transition, where associative genomic data have paved the way for mechanistic studies of the biochemical and chemical mechanisms that underlie plant-microbiome interactions. These new mechanistic discoveries are key, as they enable engineering strategies to modify and enhance the microbiome to benefit plant fitness in a changing climate.
Using core competencies in metabolic chemistry, microbiology, and synthetic biology, we study the chemical and biochemical basis of plant-microbe interactions. Rooted in discovery science, we investigate and apply newfound knowledge in the following research areas:



Plants exude up to 40% of their fixed carbon in the form of sugars, amino acids, fatty acids, and other secondary metabolites. Unsurprisingly, the profile of these nutrients and bioactive compounds is influenced by climate-related stressors and has a profound impact on the structure and composition of the plant microbiome. An improved understanding of how climate-related stressors modify chemical exudation profiles and how these changes dictate the function of the microbiome would enable targeted approaches to design and build fit-for-purpose plant-microbe interactions to improve climate resilience.
Our lab leverages genetic and metabolomic screening approaches to better understand the important chemical interactions that plants use to select for particular microbes in the rhizosphere. We are particularly interested in understanding the impact that climate-related stressors (e.g. heat, cold, drought, UV, pathogen stress) have on chemical exudation profiles and how these changes impact particular keystone microbes in the rhizosphere. We use the mechanistic insight gained during our research to develop engineering interventions to improve crop health and yield.



While microbiome-based technologies hold tremendous promise for improving human health, environmental sustainability, and crop productivity, these products all face a similar grand challenge: lack of colonization. While the human therapeutics discipline has been able to overcome some of these challenges with antibiotic use and frequent dosing regimens, these strategies are untenable for agricultural products. An improved understanding of biochemical and chemical factors that dictate colonization of microbes on crops can propel technological development and increase the efficacy of sustainable microbial fertilizers and interventions.
Our lab leverages evolutionary insights and synthetic biology to discover and understand specific mechanisms that are critical for microbial colonization in the rhizosphere. Our strategic approaches enable us to uncover novel genetic, biochemical, and chemical factors in plants and microbes that contribute toward selection and retention of microbes at the soil-root interface. We aim to uncover insights that will enable the field to develop synthetic plant-microbe pairs that can be deployed to reliably improve crop yield in dynamic field conditions.



Our lab is dedicated to translating fundamental scientific discoveries to engineered applications with transformational potential in agriculture. Toward this end, we partner with the Deep Soil Ecotron, a state-of-the-art NSF-funded facility housed at the University of Idaho that enables precise control of above and belowground environmental parameters to accurately replicate real-world plant growth and soil conditions. The precise control enabled by the this facility enables us to more accurately evaluate climate-related impacts on the microbiome and evaluate microbial bioproducts in real-world simulated conditions. Our relationships with the Deep Soil Ecotron and the extensive network of University of Idaho agricultural research and extension centers enable us to critically evaluate the potential of microbial bioproducts in agriculture.


Holmes, E.C., Chen, Y-C., Mudgett, M.B., & Sattely, E.S. (2021). Arabidopsis UGT76B1 glycosylates N-hydroxy-pipecolic acid and inactivates systemic acquired resistance in tomato. The Plant Cell. koaa052.Holmes, E.C., Chen, Y-C, Sattely, E.S., & Mudgett, M.B. (2019). An engineered pathway for N-hydroxy pipecolic acid synthesis enhances systemic acquired resistance in tomato. Science Signaling 12(604).Chen, Y.-C., Holmes, E.C., Rajniak, J., Kim, J.-G., Tang, S., Fischer, C.R., Mudgett, M.B., & Sattely, E.S. (2018). N-hydroxy-pipecolic acid is a mobile metabolite that induces systemic disease resistance in Arabidopsis. Proceedings of the National Academy of Sciences, 115(21), E4920–E4929.
Holmes, E.C., Breunig, S., Bleem, A.C., Johnson, C.W., & Beckham, G.T. (2025). Insights into genetic determinants of volatile fatty acid catabolism in Cupriavidus necator H16. Appl. Environ. Microbiol. e00515-25.Holmes, E.C., Bleem, A.C., Johnson, C.W., & Beckham, G.T. (2024). Adaptive laboratory evolution and metabolic engineering of Cupriavidus necator for improved catabolism of volatile fatty acids. Metabolic Engineering. 86, 262-273.Karim, A., Gestaut, D.R., Fincker, M., Ruth, J.C., Holmes, E.C., Sheu, W., & Spormann, A.M. (2018). Fine-Tuned Protein Production in Methanosarcina acetivorans C2A. ACS Synthetic Biology, 7(8), 1874–1885.Doud, D.F.R., Holmes, E.C., Richter, H., Molitor, B., Jander, G., & Angenent, L.T. (2017). Metabolic engineering of Rhodopseudomonas palustris for the obligate reduction of n-butyrate to n-butanol. Biotechnology for Biofuels, 10(1), 1–11.Sureka, S., Chakravorty, A., Holmes, E.C., Spassibojko, O., Bhatt, N., Wu, D., & Turgeon, B.G. (2014). Standardization of functional reporter and antibiotic resistance cassettes to facilitate the genetic engineering of filamentous fungi. ACS Synthetic Biology, 3(12), 960–962.Webster, D.P., TerAvest, M.A., Doud, D.F.R., Chakravorty, A., Holmes, E.C., Radens, C.M., … Angenent, L. T. (2014). An arsenic-specific biosensor with genetically engineered Shewanella oneidensis in a bioelectrochemical system. Biosensors and Bioelectronics, 62, 320–324.
Uekert, T., Bleem, A.C., Holmes, E.C., Pal, A., Johnson, C.W., & Beckham, G.T. (2025). Coupling waste feedstocks to microbial protein production in a circular food system. ACS Sus. Chem. & Eng.13, 709-724.Nguyen, M., Holmes, E.C., & Angenent, L.T. (2021). The short-term effect of residential home energy retrofits on indoor air quality and microbial exposure: a case-control study. PLoS ONE 16(9).


PhD | Chemical Engineering | Stanford University | 2021
BS | Biological Engineering | Cornell University | 2016
In the lab | During his graduate work in Elizabeth Sattely’s lab at Stanford, Eric developed metabolic and genetic screening approaches to discover and engineer metabolite-based pathogen defense mechanisms in plants. Post-PhD, Eric spent several years in industry, working with microbiome therapeutic startups to develop novel genetic engineering tools and strategies for bacterial-based therapeutics. He then transitioned to a Postdoctoral Researcher position at the National Renewable Energy Laboratory, where he worked in Gregg Beckham’s group to develop strategies for producing sustainable food products from waste resources. In 2025, Eric started his lab at the University of Idaho, where he leverages expertise in plant chemistry, metabolomics, microbiology, and synthetic biology to uncover and engineer the mechanisms that underlie critical interactions between plants and microbes.Out of lab | Eric was born and raised in Oregon and spends his spare time taking full advantage of the Pacific Northwest’s many recreational and cultural opportunities. In particular, he enjoys backpacking, fly fishing, wildlife photography, road biking, vegetable gardening, and devising fresh pasta dishes with his family.


Sarah is an undergraduate researcher majoring in Biological Engineering. She is working to develop novel bacterial inoculants to combat plant-parasitic nematode infections in potato.

Milo is a research aide from Moscow, ID. His work is focused on understanding metabolic interactions between microbes and wheat, with the goal of improving agricultural yields on the Palouse.